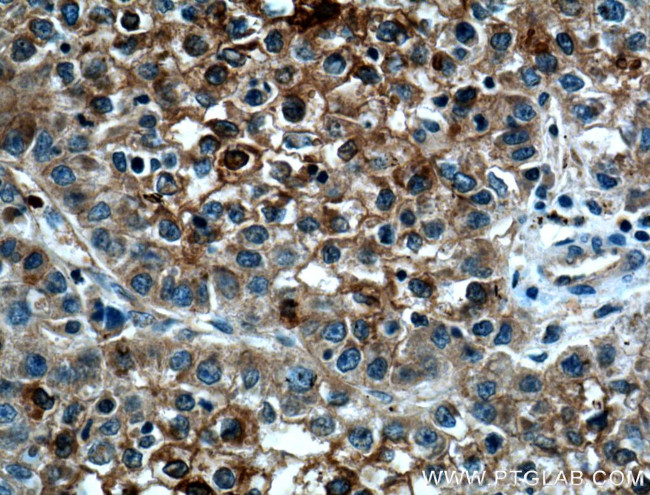
CYP2A6 Antibody in Immunohistochemistry (Paraffin) (IHC (P))

Search
Proteintech
CYP2A6 Polyclonal Antibody
{{$productOrderCtrl.translations['antibody.pdp.commerceCard.promotion.promotions']}}
{{$productOrderCtrl.translations['antibody.pdp.commerceCard.promotion.viewpromo']}}
{{$productOrderCtrl.translations['antibody.pdp.commerceCard.promotion.promocode']}}: {{promo.promoCode}} {{promo.promoTitle}} {{promo.promoDescription}}. {{$productOrderCtrl.translations['antibody.pdp.commerceCard.promotion.learnmore']}}
产品信息
21721-1-AP
种属反应
已发表种属
宿主/亚型
分类
类型
抗原
偶联物
形式
浓度
规格
纯化类型
保存液
内含物
保存条件
运输条件
产品详细信息
Immunogen sequence: FLSLLRMML GIFQFTSTST GQLYEMFSSV MKHLPGPQQQ AFQLLQGLED FIAKKVEHNQ RTLDPNSPRD FIDSFLIRMQ EEEKNPNTEF YLKNLVMTTL NLFIGGTETV STTLRYGFLL LMKHPEVEAK VHEEIDRVIG KNRQPKFEDR AKMPYMEAVI HEIQRFGDVI PMSLARRVKK DTKFRDFFLP KGTEVYPMLG SVLRDPSFFS NPQDFNPQHF LNEKGQFKKS DAFVPFSIGK RNCFGEGLAR MELFLFFTTV MQNFRLKSSQ SPKDIDVSPK HVGFATIPRN YTMSFLPR (198-494 aa encoded by BC096253)
靶标信息
This gene, CYP2A6, encodes a member of the cytochrome P450 superfamily of enzymes. The cytochrome P450 proteins are monooxygenases which catalyze many reactions involved in drug metabolism and synthesis of cholesterol, steroids and other lipids. This protein localizes to the endoplasmic reticulum and its expression is induced by phenobarbital. The enzyme is known to hydroxylate coumarin, and also metabolizes nicotine, aflatoxin B1, nitrosamines, and some pharmaceuticals. Individuals with certain allelic variants are said to have a poor metabolizer phenotype, meaning they do not efficiently metabolize coumarin or nicotine. This gene is part of a large cluster of cytochrome P450 genes from the CYP2A, CYP2B and CYP2F subfamilies on chromosome 19q. The gene was formerly referred to as CYP2A3; however, it has been renamed CYP2A6.
仅用于科研。不用于诊断过程。未经明确授权不得转售。
生物信息学
蛋白别名: 1,4-cineole 2-exo-monooxygenase; Coumarin 7-hydroxylase; CYP; CYPIIA6; Cytochrome P450 2A6; Cytochrome P450 IIA3; Cytochrome P450(I); cytochrome P450, family 2, subfamily A, polypeptide 6; cytochrome P450, subfamily IIA (phenobarbital-inducible), polypeptide 6; cytochrome P450IIA3; flavoprotein-linked monooxygenase; P450; P450 IIA3; P450(I); unnamed protein product; xenobiotic monooxygenase
基因别名: CPA6; CYP2A; CYP2A3; CYP2A6; CYPIIA6; P450C2A; P450PB
UniProt ID: (Human) P11509
Entrez Gene ID: (Human) 1548